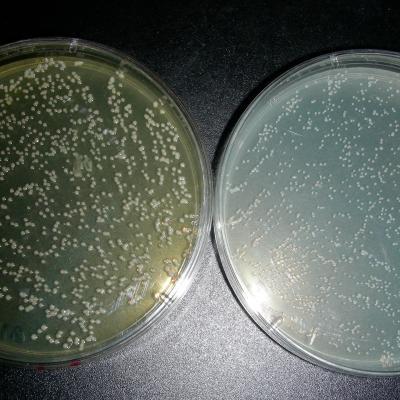

REPRODIVAC - Next-generation vaccines and diagnostics to prevent livestock reproductive diseases of worldwide impact
REPRODIVAC has received funding from the European Union’s Horizon Europe research and innovation programme under Grant Agreement No. 101060813. Views and opinions expressed are however those of the author(s) only and do not necessarily reflect those of the European Union or other granting authorities. Neither the European Union nor the other granting authorities can be held responsible for them.

REPRODIVAC has received funding from the European Union’s Horizon Europe research and innovation programme under Grant Agreement No. 101060813. Views and opinions expressed are however those of the author(s) only and do not necessarily reflect those of the European Union or other granting authorities. Neither the European Union nor the other granting authorities can be held responsible for them.